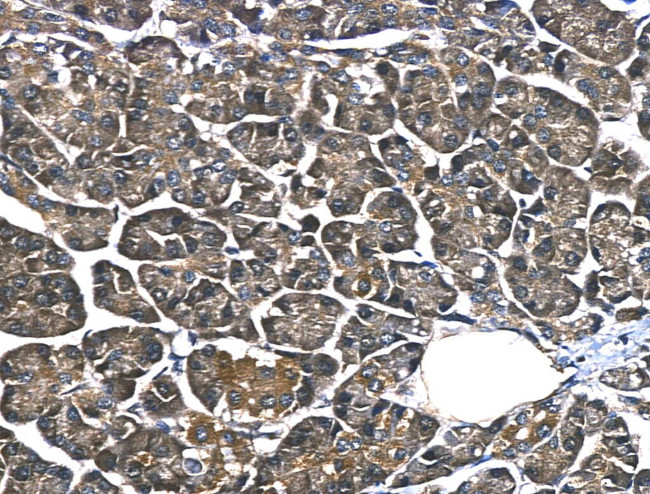
HnRNP Q Antibody in Immunohistochemistry (Paraffin) (IHC (P))

Search
Invitrogen
HnRNP Q Polyclonal Antibody
{{$productOrderCtrl.translations['antibody.pdp.commerceCard.promotion.promotions']}}
{{$productOrderCtrl.translations['antibody.pdp.commerceCard.promotion.viewpromo']}}
{{$productOrderCtrl.translations['antibody.pdp.commerceCard.promotion.promocode']}}: {{promo.promoCode}} {{promo.promoTitle}} {{promo.promoDescription}}. {{$productOrderCtrl.translations['antibody.pdp.commerceCard.promotion.learnmore']}}
图: 1 / 3
HnRNP Q Antibody (PA5-99420) in IHC (P)



Please note: We are reviewing Western blot images included in the antibody testing data in our catalog, including those provided by third parties. Unless expressly labeled or annotated as “raw-unedited”, Western blot images included in the antibody testing data in our catalog may have been edited, optimized or otherwise adjusted for presentation.
产品信息
PA5-99420
种属反应
宿主/亚型
分类
类型
抗原
偶联物
形式
浓度
规格
纯化类型
保存液
内含物
保存条件
运输条件
RRID
产品详细信息
Antibody detects endogenous levels of total hnRNP Q.
靶标信息
Heterogenous nuclear ribonucleoprotein (hnRNP) implicated in mRNA processing mechanisms. Component of the CRD-mediated complex that promotes MYC mRNA stability. Isoform 1, isoform 2 and isoform 3 are associated in vitro with pre-mRNA, splicing intermediates and mature mRNA protein complexes. Isoform 1 binds to apoB mRNA AU-rich sequences. Isoform 1 is part of the APOB mRNA editosome complex and may modulate the postranscriptional C to U RNA-editing of the APOB mRNA through either by binding to A1CF (APOBEC1 complementation factor), to APOBEC1 or to RNA itself. May be involved in translationally coupled mRNA turnover. Implicated with other RNA-binding proteins in the cytoplasmic deadenylation/translational and decay interplay of the FOS mRNA mediated by the major coding-region determinant of instability (mCRD) domain. Interacts in vitro preferentially with poly(A) and poly(U) RNA sequences. Isoform 3 may be involved in cytoplasmic vesicle-based mRNA transport through interaction with synaptotagmins. Component of the GAIT (gamma interferon-activated inhibitor of translation) complex which mediates interferon-gamma-induced transcript-selective translation inhibition in inflammation processes. Upon interferon-gamma activation assembles into the GAIT complex which binds to stem loop-containing GAIT elements in the 3'-UTR of diverse inflammatory mRNAs (such as ceruplasmin) and suppresses their translation; seems not to be essential for GAIT complex function.
仅用于科研。不用于诊断过程。未经明确授权不得转售。
篇参考文献 (0)
生物信息学
蛋白别名: Glycine- and tyrosine-rich RNA-binding protein; GRY-RBP; Heterogeneous nuclear ribonucleoprotein Q; hnRNP; hnRNP Q; hnRNP-Q; Liver regeneration-related protein LRRG077; NS1-associated protein 1; pp68; RRM RNA binding protein; RRM RNA binding protein GRY-RBP; similar to Homo sapiens Hn RNP R; Synaptotagmin-binding, cytoplasmic RNA-interacting protein; unnamed protein product
基因别名: 2610109K23Rik; 4632417O19Rik; Ab2-339; GRY-RBP; GRYRBP; hnRNP-Q; HNRNPQ; HNRPQ; HNRPQ1; NSAP1; Nsap1l; PP68; SYNCRIP
UniProt ID: (Rat) Q7TP47, (Mouse) Q7TMK9
Entrez Gene ID: (Human) 10492, (Rat) 363113, (Mouse) 56403